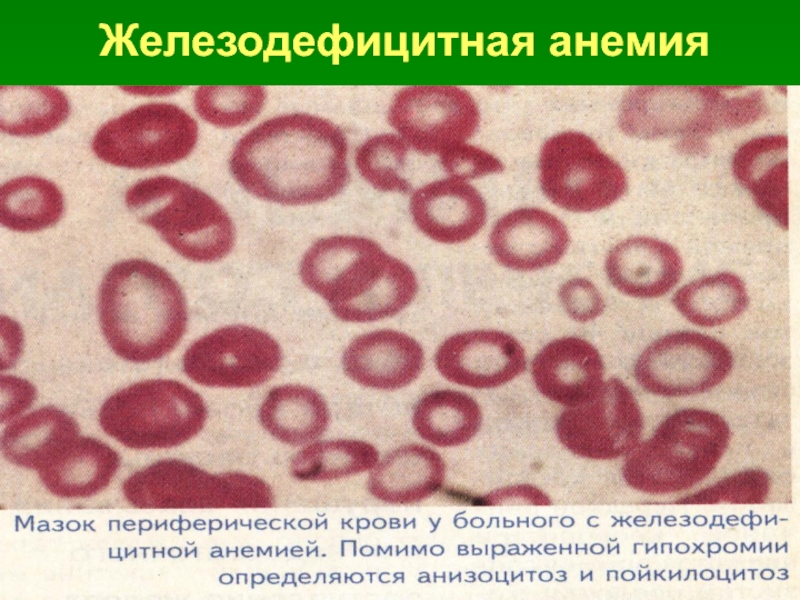

Разделы презентаций
- Разное
- Английский язык
- Астрономия
- Алгебра
- Биология
- География
- Геометрия
- Детские презентации
- Информатика
- История
- Литература
- Математика
- Медицина
- Менеджмент
- Музыка
- МХК
- Немецкий язык
- ОБЖ
- Обществознание
- Окружающий мир
- Педагогика
- Русский язык
- Технология
- Физика
- Философия
- Химия
- Шаблоны, картинки для презентаций
- Экология
- Экономика
- Юриспруденция
Анемии
Содержание
- 1. Анемии
- 2. Группы анемий (Воробьёв А.И., Баркаган З.С., 1985)Острая
- 3. Степень тяжести анемииЛёгкая: Hb
- 4. Значения цветового показателя (Farben Index)Нормохромная: 0,9
- 5. Значения среднего диаметра эритроцитовНормоцитарные:
- 6. Возможность регенерацииРегенераторная (достаточна функция костного мозга)Гипорегенераторная (компенсация в результате лечения)Арегенераторная (резкое угнетение эритропоэза)
- 7. Классификация железодефицитных анемийХронические пост-геморрагические1. Гиперполименорея, роды, аборты2. Хронические кровотечения ж/к тракта3. Носовые кровотечения
- 8. Классификация железодефицитных анемийПовышенная потребность в Fe1.Беременность, лактация2. Период бурного роста организма3. Период полового созревания
- 9. Классификация железодефицитных анемийНарушения поступления FeНарушения транспорта Fe1.
- 10. Развитие дефицита Fe в организмеI Этап.
- 11. Развитие дефицита Fe в организмеII Этап.
- 12. Развитие дефицита Fe в организмеIII Этап. Железодефицитная анемия:Страдают все фонды
- 13. Слайд 13
- 14. Железодефицитная анемия
- 15. Этапы терапии железодефицитной анемии1. Этап: до
- 16. Витамин B12 – дефицитная анемия
- 17. Этиология дефицита витамина B12Нарушение всасывания B12
- 18. Этиология дефицита витамина B12Конкурентное поглощение B12ДефилоботриозИзменение микрофлоры кишечника после резекции кишки
- 19. Этиология дефицита витамина B12Нарушение поступления B12Нарушение транспорта B121. ВегетарианствоОтсутствиетранскобаламина-22. Антитела к B12
- 20. Патогенез Фолиевая кислотаМетилкобаламин 5-10-метилентетрагидрохолевая кислотаУрединмонофосфат тимидин
- 21. ПатогенезНарушение синтеза ДНКУтрата способности к митозуклеток красного росткаОставаясь крупными, клетки дифференцируются и созреваютМегалобласты, мегалоциты, макроциты
- 22. Патогенез Дефицит ДезоксиаденозилкабаламинаНарушение синтеза жирных кислотНарушение образования миелинаПовреждение аксоновполиневрит
- 23. Патогенез Дефицит ДезоксиаденозилкабаламинаНарушение распада жирных кислотОбразования пропионовой,
- 24. B12 – дефицитная анемия
- 25. B12 – дефицитная анемия
- 26. Этапы терапии B12 – дефицитной анемии
- 27. Гемолитические анемии Группа анемий, при которых гемолиз (разрушение эритроцитов) преобладает над эритропоэзом.
- 28. Гемолитические анемииN : продолжительность жизни эритроцита в
- 29. Классификация гемолитических анемийI Наследственные (врождённые): 1.
- 30. Классификация гемолитических анемийI Наследственные (врождённые): 1.
- 31. Классификация гемолитических анемий3. Ферментопатии:
- 32. Классификация гемолитических анемийII Приобретённые: 1.
- 33. Классификация гемолитических анемий 5.
- 34. ПатогенезN: Внутриклеточный гемолиз - Эритроциты разрушаются фагоцитируюшими
- 35. Повышенный внутриклеточный гемолиз Кол-во Эр
- 36. Повышенный внутрисосудистый гемолиз Кол-во Эр
- 37. По клиническому течению при внутриклеточном гемолизе: Латентная
- 38. Гемолитический криз Подострая форма: - возникает
- 39. Гемолитический криз при внутрисосудистом гемолизе Подострая форма:
- 40. Осложнения:При значительном распаде эритроцитов
- 41. Наследственный микросфероцитоз Распространена в Европе 1 :
- 42. Наследственный микросфероцитоз
- 43. Наследственный микросфероцитозКлиника по варианту повышенного внутриклеточного гемолиза;
- 44. Наследственный микросфероцитозВрождённые аномалии развития:
- 45. Наследственный микросфероцитозОсложнение: -
- 46. Диагностика Общий анализ крови:
- 47. ДиагностикаМазок крови – Микросфероцитоз; ________________________________________ Больная Н.
- 48. Диагностика Осмотическая резистентность эритроцитов:
- 49. ДиагностикаПовышен аутогемолиз: - инкубация
- 50. Диагностика Продолжительность жизни Эр, меченных Cr 51
- 51. Лечение Спленэктомия – основной метод
- 52. Скачать презентанцию
Группы анемий (Воробьёв А.И., Баркаган З.С., 1985)Острая постгеморрагическая Железодефицитные Сидероахрестические Анемии вследствие нарушения синтеза ДНК и РНКГемолитические Гипо- и апластические
Слайды и текст этой презентации
Слайд 1Анемии
Е.М. Идрисова - профессор кафедры факультетской терапии с курсом клинической
фармакологии СибГМУ,
Слайд 2Группы анемий
(Воробьёв А.И., Баркаган З.С., 1985)
Острая постгеморрагическая
Железодефицитные
Сидероахрестические
Анемии
вследствие нарушения синтеза ДНК и РНК
Гемолитические
Гипо- и апластические
Слайд 3Степень тяжести анемии
Лёгкая: Hb до 100 г/л,
Эр > 3,0•10 12/л
Средняя: Hb 100-66 г/л,
Эр 3,0-2,0•10 12/л
Тяжёлая: Hb < 66 г/л,
Эр < 2,0•10 12/л
Слайд 4Значения цветового показателя (Farben Index)
Нормохромная: 0,9 – 1,0
Гипохромная:
< 0,9
Гиперхромная: > 1,0
3 Hb г/л
Цв. п-ль = три первые цифры
числа Эр в млн.
Слайд 5Значения среднего диаметра эритроцитов
Нормоцитарные:
СДЭ = 7,2 - 8,0
мкмМикроцитарные:
СДЭ < 7,2 мкм
Макроцитарные:
СДЭ > 8,1 – 9,5 мкм
Слайд 6Возможность регенерации
Регенераторная
(достаточна функция костного мозга)
Гипорегенераторная
(компенсация
в результате лечения)
Арегенераторная
(резкое угнетение эритропоэза)
Слайд 7Классификация железодефицитных анемий
Хронические пост-геморрагические
1. Гиперполименорея, роды, аборты
2. Хронические кровотечения ж/к
тракта
3. Носовые кровотечения
Слайд 8Классификация железодефицитных анемий
Повышенная потребность в Fe
1.Беременность, лактация
2. Период бурного роста
организма
3. Период полового созревания
Слайд 9Классификация железодефицитных анемий
Нарушения поступления Fe
Нарушения транспорта Fe
1. Недостаток
поступления
с пищей
2. Нарушения
всасывания
1. Атрансферринемия
2. АТ к трансферрину
3. Массивная
протеинурияСлайд 10Развитие дефицита Fe
в организме
I Этап.
Прелатентный дефицит Fe:
1. Нет клинических проявлений
2. Нет анемии3. Fe сыворотки крови в N
4. Снижен запасной фонд
( плазменный ферритин)
Слайд 11Развитие дефицита Fe
в организме
II Этап. Клинически латентный дефицит Fe:
1. Клиника дефицита Fe в тканях
(снижены: запасной фонд – ферритин, тканевой – окислительные ферменты
транспортный - трансферрин)
2. Нет анемии
(основной фонд эритрона N)
3. Fe сыворотки , ОЖСС,
коэффициент насыщения
Fe трансферрина
Слайд 15Этапы терапии
железодефицитной анемии
1. Этап: до нормализации Hb
лечебные дозы 1 – 1,5 месяца
2. Этап: восполнение запасов
Fe3. Этап: профилактический
(если источник кровопотери
не устранён) - 10 дней ежемесячно
лечебные дозы
Слайд 17Этиология дефицита
витамина B12
Нарушение всасывания B12
Секреции
гастромукопротеина
Болезни тонкого кишечника
Функции pancreas
( трипсина)
Слайд 18Этиология дефицита
витамина B12
Конкурентное поглощение B12
Дефилоботриоз
Изменение микрофлоры кишечника после резекции
кишки
Слайд 19Этиология дефицита
витамина B12
Нарушение поступления B12
Нарушение транспорта B12
1. Вегетарианство
Отсутствие
транскобаламина-2
2. Антитела
к B12
Слайд 20Патогенез
Фолиевая кислота
Метилкобаламин
5-10-метилентетрагидрохолевая
кислота
Урединмонофосфат тимидин
Слайд 21Патогенез
Нарушение синтеза ДНК
Утрата способности к митозу
клеток красного ростка
Оставаясь крупными, клетки
дифференцируются и созревают
Мегалобласты,
мегалоциты, макроциты
Слайд 22Патогенез
Дефицит
Дезоксиаденозилкабаламина
Нарушение синтеза жирных кислот
Нарушение образования миелина
Повреждение аксонов
полиневрит
Слайд 23Патогенез
Дефицит
Дезоксиаденозилкабаламина
Нарушение распада жирных кислот
Образования пропионовой, метилмалоновой кислот
Токсическое действие
на задние
и боковые рога спинного мозга
Фуникулярный миелоз
Слайд 26Этапы терапии
B12 – дефицитной анемии
1. Этап: до нормализации
Hb
1 – 1,5 месяца 200-500 мкг/день
на 5-8 день
терапии – ретикулоциты до 20-30%2. Этап: восполнение запасов B12
1,5-2 месяца 200-500 мкг/нед.
3. Этап: профилактический
(если источник кровопотери не устранён) – 15-20 дней 1 р/год 200- 500мкг/день
Слайд 27Гемолитические анемии
Группа анемий, при которых
гемолиз
(разрушение эритроцитов)
преобладает
над
эритропоэзом.
Слайд 28Гемолитические анемии
N : продолжительность жизни эритроцита в среднем 120 дней
При гемолитической анемии –
снижается до 12 –
20 днейСлайд 29Классификация гемолитических анемий
I Наследственные (врождённые):
1. Мембранопатии:
Микросфероцитарная анемия
(болезнь Минковского
- Шоффара),Овалоцитоз,
Стоматоцитоз
2. Гемоглобинопатии:
Талассемия
Серповидноклеточная анемия и др.
Слайд 30Классификация гемолитических анемий
I Наследственные (врождённые):
1. Мембранопатии:
Микросфероцитарная анемия
(болезнь Минковского
- Шоффара),Овалоцитоз,
Стоматоцитоз
2. Гемоглобинопатии:
Талассемия
Серповидноклеточная анемия
Слайд 31Классификация гемолитических анемий
3. Ферментопатии:
при дефиците: Г-6-ФГ
(глюкозо-6
фосфатдегидрогеназы),
глутатион-редуктазы,
пируваткиназы4. Нормобластоз плода
(Гемолитическая болезнь новорождённых)
Слайд 32Классификация гемолитических анемий
II Приобретённые:
1. Аутоиммунные
2. Пароксизмальная ночная гемоглобинурия
(болезнь
Маркьяфавы-Микели)3. Связанные с механическим повреждением
мембраны эритроцита
4. Анемии вследствие отравления гемолитическими
ядами: свинец, тяжёлые металлы,
органические кислоты, амилнитрит и др.
Слайд 33Классификация гемолитических анемий
5. Вследствие вливания несовместимой
по группе или резус
фактору крови6. Вследствие недостатка витамина Е
7. Связанные с воздействием паразитов
(малярия)
Слайд 34Патогенез
N: Внутриклеточный гемолиз - Эритроциты разрушаются фагоцитируюшими мононуклеарами:
в
селезёнке – малоизменённые
стареющие эритроциты,в костном мозге – эритрокариоциты,
в печени – эритроциты, нагруженные АТ
с патологически изменённой
мембраной.
N: Внутрисосоудистый гемолиз:
небольшое количество особо
грубо изменённых эритроцитов
Слайд 35Повышенный внутриклеточный гемолиз
Кол-во Эр
Свободный (непрямой) Спленомегалия
Анемический билирубин в крови -
синдром Желтуха с лимонным оттенком
Ретикулоциты в печени: образования
4-5% связанного (прямого) билирубина
Плейохромия - интенсивная
В костном мозге: окраска желчи, Холелитиаз
Эритробластов (билирубин +\ - ХС), ЖКБ
Нормоцитов Гепатомегалия – не всегда
Стеркобилиноген и уробилиноген
в кишечнике интенсивно окрашен кал
Уробилин в моче
Моча цвета тёмного пива
Слайд 36Повышенный внутрисосудистый гемолиз
Кол-во Эр
Свободный (непрямой)
Анемический билирубин в крови -
синдром Желтуха с лимонным оттенком
Ретикулоциты свободный Hb
4-5% выделяется с мочой
Hb-урия,
В костном мозге: гемосидеринурия -
Эритробластов красная, бурая,
Нормоцитов чёрная моча
Гемосидероз
внутренних органов
Слайд 37По клиническому течению при внутриклеточном гемолизе:
Латентная (компенсированная) форма:
-
нет выраженной анемии и желтухи
- клиника ЖКБ, холангиогепатита
Хроническая форма:- небольшая желтуха, анемия,
- ретикулоцитоз. СОЭ,
- нередко субфебрильная t°, артралгии
Слайд 38Гемолитический криз
Подострая форма:
- возникает на фоне хронического течения;
- внезапно t° до 38° - 39° с
ознобом;- боли животе в левом и правом подреберье
(часто увеличение печени и селезёнки);
- слабость, одышка - Эр, Hb, СОЭ
ретикулоцитоз;
- усиление желтухи с лимонным оттенком -
непрямой билирубин;
- моча цвета тёмного пива – уробилин;
- тёмный кал - стеркобилин;
Слайд 39Гемолитический криз при внутрисосудистом гемолизе
Подострая форма:
- внезапно
t° до 38° - 39° с ознобом,;
-
головная боль, боли в пояснице;- боли животе, тошнота, рвота с большим
количеством желчи;
- слабость, одышка - Эр, Hb, СОЭ
ретикулоцитоз,
- усиление желтухи с лимонным оттенком –
непрямой билирубин
- моча цвета тёмного пива – уробилин
- тёмный кал - стеркобилин
Слайд 40Осложнения:
При значительном распаде эритроцитов
освобождение
эритроцитарного
тромбопластического фактора
ДВСОПН
Кома
Слайд 41Наследственный микросфероцитоз
Распространена в Европе 1 : 5000,
редко
в Японии, Африке;
Наследуется по доминантному типу аутосомно
Но у
20% больных нет заболевания у родителей – мутация половых клеток; Слайд 42Наследственный микросфероцитоз
Дефицит
или аномальный белок
мембраны эритроцитов – спектринв костном мозге продукция
микросфероцитов, проницаемость
для Na - набухание Эр.
нарушена способность к деформации
в узких местах кровотока (селезёнка)
Гемолиз
Слайд 43Наследственный микросфероцитоз
Клиника по варианту повышенного внутриклеточного гемолиза;
3 формы течения:
латентная, хроническая, подострая;
Провоцируюшие факторы:
- инфекции
- переохлаждение- травма
- переутомление
- беременность
Слайд 44Наследственный микросфероцитоз
Врождённые аномалии развития:
- башенный череп
- заячья губа
- микрофтальмия
- готическое нёбо
- изменение расположения зубов
- укорочение мизинцев
- пороки сердца
Слайд 46Диагностика
Общий анализ крови:
- период
ремиссии: Эр, Hb, – N или
- период криза: резкое Эр, Hb, СОЭ, LРетикулоцитоз, цв п-ль 0,9 - 1;
________________________________________
Больная Н. Ремиссия Криз
Hb 105 г/л 61 г/л
Эр 3,04 ▪ 1012 2,02 ▪ 1012
цв. п-ль 0,9 0,9
СОЭ 4 мм/ч 50 мм/ч
L 6,6 ▪ 109 7,2 ▪ 109
Слайд 47Диагностика
Мазок крови – Микросфероцитоз;
________________________________________
Больная Н. Микросфероциты 36%
N до 12,5%
СДЭ 6,86 (N 7,2 – 8,0)
Биохимия крови: Непрямой билирубин
Больная Н. Билирубин 30,7 – 58,0 ммоль/л
прямой билирубин – 8,0
(N Билирубин 8,0 – 20,5)
прямой – до 2,57
Слайд 48Диагностика
Осмотическая резистентность эритроцитов:
- начало гемолиза
– при 0,8 – 0,6% р-р NaCl
- полный гемолиз – при 0,4% р-р NaClN: начало гемолиза - при 0,42- 0,46% р-р NaCl
полный гемолиз – при 0,32- 0,34% р-р NaCl
__________________________________________
Больная Н. Min 0,64%
Max 0,4%
Слайд 49Диагностика
Повышен аутогемолиз:
- инкубация Эр при t°=
37° ~ 48 ч –
гемолиз
не менее 30% Эр (N: 3- 4%)Положительная проба с АТФ и глюкозой:
(снижение гемолиза при добавлении)
Метод кислотных эритрограмм (строго специфична)
- резкое удлинение гемолиза
Слайд 50Диагностика
Продолжительность жизни Эр, меченных Cr 51
Проба Кумбса -
чаще отрицательная
Больная Н. – отриц.УЗИ: холелитиаз, селезёнки
Больная Н. – холелитиаз,
спленомегалия
Слайд 51Лечение
Спленэктомия – основной метод
Показания:
- тяжёлое течение с частыми кризами;
- значительное билирубина;- болевой синдром в области печени;
- отставание в развитии у детей
Профилактика тромбозов после операции
Трансфузии эритроцитарной массы – только при тяжёлой анемии после криза